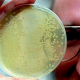
Египетская шамбала наказала Европу

Александра Полякова
Александра Полякова — бывший корреспондент новостной службы NewsInfo

Материалы автора (229)
 2011-07-15 14:48.00
2011-07-15 14:48.00
Смертельно измученное лицо, неестественно-серьезная гримаса на паспортном фото давно вышли из моды. В Европе новый тренд: всяческого рода приколы и издевательства. Высуньте язык, наденьте на голову необычный головной убор – и все равно не нарушите таким образом самое гуманное в мире европейское законодательство. Этот факт доказал на днях австриец Нико Альм, которому власти, хоть и после долгого раздумья, разрешили сфотографироваться с дуршлагом на голове как адепту юной макаронной религии.
Читать полностью » 2011-07-14 16:37.00
2011-07-14 16:37.00
В борьбе с комарами все средства хороши. Одни обливаются слезами, потому что натерлись луком, другие страдают от бессонницы из-за прокипяченной в корице марли на окне. Третьи, не боясь аллергии, опрыскиваются антистатиком и ополаскивателем для рта. Но ученые считают: пора объявить гнусу мировую войну. Речь уже не идет о банальном распылении убийственных химикатов. У современной науки в арсенале куда более грозное оружие. Танзанийские специалисты предлагают победить комаров… грязными носками.
Читать полностью » 2011-07-13 14:06.00
2011-07-13 14:06.00
В прокат выходит заключительная часть киносаги о Гарри Потере под названием "Гарри Поттер и дары смерти: Часть II". В ней повзрослевший главный герой одолевает, наконец, своего смертельного врага Волан-де-Морта. Миллионы фанатов уже сейчас содрогаются при мысли о том, что никогда больше не увидят полюбившихся им героев на большом экране. Но не преждевременна ли ранняя скорбь и не будет ли продолжения у этой доходной истории? Как говорит создательница поттерианы Джоан Роулинг, never say never.
Читать полностью » 2011-07-12 17:55.00
2011-07-12 17:55.00
Вот и завершился первый официальный зарубежный визит герцога и герцогини Кембриджских, который они нанесли в Канаду и США. На протяжении десяти дней репортеры всего мира имели возможность смаковать подробности путешествия – наряды Кейт и ее умение преподать себя, умные государственные речи принца, ну и, конечно же, досадные заминки, без которых тоже не обошлось. В целом можно сказать, что экзамен журналистскому пулу и взыскательной общественности Кейт и Уильям сдали. Впрочем, не без ложки дегтя.
Читать полностью » 2011-07-07 14:04.00
2011-07-07 14:04.00
История с кишечной инфекцией E.coli плавно приближается к развязке. По крайней мере, голоса экспертов в ЕС зазвучали куда более слаженно и уверенно, чем раньше. Вероятно, потому, что впервые козлом отпущения была названа неевропейская страна. По заключению официальной экспертизы, смертоносная бактерия была завезена в Европу в 2009 году с партией египетских семян шамбалы. И хотя Каир свою вину не признает, российский Роспотребнадзор вслед за еврокомиссарами ввел запрет на импорт продуктов египетского растениеводства.
Читать полностью » 2011-07-06 15:20.00
2011-07-06 15:20.00
Слушания по делу Ратко Младича превратились в цирк гораздо быстрее, чем ожидалось. Самый «беспристрастный» трибунал в мире удалил генерала из зала заседаний якобы из-за непотребного поведения. Но до сих пор непотребной остается только позиция мирового сообщества, которое, кажется, навсегда забыло о справедливости. Однако позорное судилище ударило не только по сербам, которые продали родину за еврозону. Выясняется, что миротворческие силы, призванные спасти Боснию и Герцеговину, весьма своеобразно исполняли свой долг.
Читать полностью » 2011-07-04 18:23.00
2011-07-04 18:23.00
Эпопея с распространением смертоносной палочки E.coli в Европе продолжается. То, что когда-то могло присниться лишь в страшном сне, стало реальностью - в минувшие выходные бактерию-мутанта обнаружили в чешской минеральной воде. А незадолго до этого анитарные эксперты нашли нового козла отпущения, обвинив Египет в поставках зараженных E.coli семян во Францию и Германию. Пока никто не дает ответа на вопрос, откуда взялась бактерия, европейцам остается, по всей видимости, одно - не есть, не пить и надеяться на лучшее.
Читать полностью » 2011-07-01 19:49.00
2011-07-01 19:49.00
Сегодня вечером Европа осиротеет, потеряв еще одного монаршего холостяка. Князь Монако Альбер Второй, наконец, женится на южноафриканской спортсменке Шарлин Уиттсток. Запланированные на пятницу и субботу свадебные торжества впечатляют своим размахом: здесь и бесплатные концерты, и торжественные приемы для всех жителей княжества, и именитые гости со всего света. Впрочем, не обошлось и без ложки дегтя – французская желтая пресса в угоду любителям сенсаций превратила Уиттсток в "сбежавшую невесту".
Читать полностью » 2011-06-27 15:08.00
2011-06-27 15:08.00
Неутомимая и практически неуловимая бактерия E.coli продолжает совершать смертельное турне по странам Европейского Союза. На прошлой неделе восемь случаев заболевания кишечной инфекцией были зарегистрированы на юго-западе Франции, недалеко от города Бордо. Эксперты всерьез опасаются, что в Германии, которая стала первой европейской страной, где была обнаружена бактерия-мутант и где в результате острого кишечного заболевания уже погибли сорок два человека, инфекция вскоре может попасть и в водопроводную воду.
Читать полностью » 2011-06-24 13:47.00
2011-06-24 13:47.00
Япония, преодолевающая последствия сокрушительного землетрясения, цунами и аварии на станции «Фукусима-1», еще раз доказывает всему миру, что такое самурайский дух и солидарность. Пока служащие компании-оператора атомной станции никак пытаются запустить аварийные работы на пострадавших реакторах на полный ход, группа инженеров-пенсионеров на добровольной основе вызвалась участвовать в мероприятиях по ликвидации последствий, аргументируя это тем, что хочет выполнить опасные работы за молодых сотрудников TEPCO.
Читать полностью » 2011-06-23 20:36.00
2011-06-23 20:36.00
Размер страны далеко не всегда имеет значение – эту закономерность еще раз выявило исследование Евростата, согласно которому уже не в первый раз самым зажиточным государством Европы был признан крошечный Люксембург. Вместе с тем, опубликованный статистический анализ покупательной способности показал, что европейская интеграция работает на благо далеко не всех , ведь большинство стран живет ниже общеевропейского уровня, а разница между самыми богатыми и самыми бедными год от года только увеличивается.
Читать полностью » 2011-06-22 14:24.00
2011-06-22 14:24.00
Солнце грозит землянам самой мощной за последние сто пятьдесят лет вспышкой, которая устроит на нашей планете сильнейшую магнитную бурю. Выведенные из строя электроприборы, спутники и радиосвязь – вот чем может обернуться подобный всплеск солнечной энергии. Впрочем, радует одно - к этому выводу пришли британские ученые, а анекдот у них в крови. Да и оппоненты утверждают, что светило будет продолжать оставаться неактивным, а скептики считают, что строить долгосрочные прогнозы космической погоды вообще нечего.
Читать полностью »




